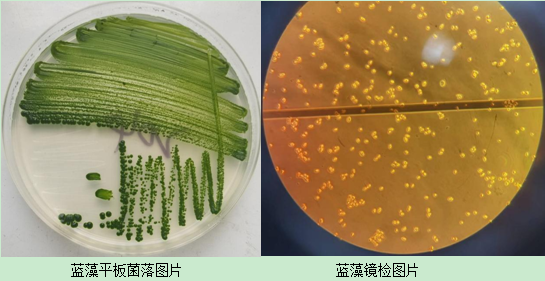
50人大型联合科考队破解世界长寿之乡生态圈微生物密码

蓝细菌

生命的开路先锋蓝细菌
图片尺寸630x473
细菌培养皿图片
图片尺寸300x300
蓝细菌,它们借助光合作用的力量造就了一个富含氧气的
图片尺寸540x375
生命的开路先锋蓝细菌
图片尺寸450x286蓝细菌
图片尺寸1200x900
人们从前寒武纪地壳中发现大量由蓝细菌(如螺旋藻)
图片尺寸640x435
蓝细菌
图片尺寸324x400
蓝细菌背景
图片尺寸700x467
50人大型联合科考队破解世界长寿之乡生态圈微生物密码
图片尺寸545x281
显微镜下放大的细菌
图片尺寸800x608
蓝色细菌素材
图片尺寸700x700
高温酷暑蓝藻爆发用这个方案调控准没错
图片尺寸1047x654
蓝细菌的五大类群
图片尺寸751x500
蓝细菌细胞,蓝细菌细胞
图片尺寸1024x1024
蓝细菌
图片尺寸439x347真实的蓝色病毒,细菌和微生物
图片尺寸1080x1200蓝细菌.
图片尺寸1100x1124
造成数百头大象水边惨死的蓝细菌,曾导致地球3亿年冰封
图片尺寸640x6213d显微镜下的蓝色细菌特写
图片尺寸1200x800
蓝色细菌向蓝色背景盐锅,特拉帕尼漫画性格关于蓝细菌
图片尺寸400x300